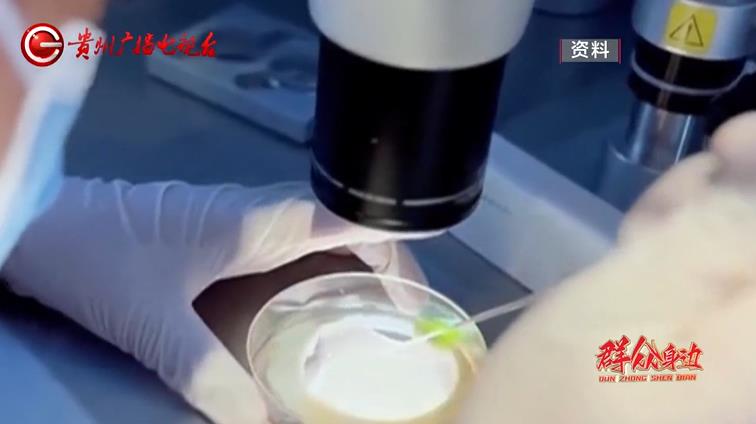

從2024年年末至2025年年初,《百姓關注》欄目連續(xù)接到多位當事人求助,稱他們通過中介咨詢公司做“試管嬰兒”時遭遇暗箱操作,不僅身心受到巨大傷害,最終還人財兩空。 這些當事人到底 經(jīng)歷了什么? 背后又有什么 不為人知的隱情呢? 夫妻為圓求子夢 花18萬重金做“試管嬰兒” 袁女士:我就是做試管被騙了,從一開始就是個騙局。 2025年1月中旬 《百姓關注》欄目接 到了市民袁女士的求助 說起一年多做“試管嬰兒”的經(jīng)歷 此時的她顯得異常絕望 袁女士:結婚十四年一直沒有孩子,2023年因為出車禍,得了一筆賠償,就想用這個錢來完成我們這個夢想。 幾年前,袁女士因特殊原因被切掉了一側的輸卵管,之后丈夫又患病,因此結婚十多年一直沒能要孩子。在拿到十多萬的事故賠償款后,她和丈夫就想著利用這筆錢來做試管嬰兒,并向醫(yī)院進行了咨詢。 袁女士:洗精這個技術,所有醫(yī)院都有,但是他們說不能單獨為我們做這個事情,所有公立醫(yī)院是不做這個事情的,醫(yī)生說他們沒有單獨的實驗室。 之后,袁女士找到了位于貴陽市南明區(qū)凱賓斯基27樓辦公的“成都市中美新生醫(yī)院管理有限公司”。在對方工作人員承諾可以做試管嬰兒后,2023年5月,袁女士與這家公司簽了一份“試管嬰兒咨詢服務合同”。合同內(nèi)容包含數(shù)十個項目,總費用為18.5萬元。 看到公司有營業(yè)執(zhí)照,袁女士放心地交了費用。袁女士說,同年11月,一名叫李如志的人打來電話,聲稱是中美新生醫(yī)院的負責人,并讓他們到成都取卵。 袁女士:早上就來接我們,我老公也不能陪我去,我的手機也被收了,給我全身掃描。當時車子全部封閉,貼了膜,窗簾也釘?shù)盟浪赖?/strong>,當時坐在車里還有點恐慌,一輛7座的商務車,據(jù)我老公說的那個牌子叫邁巴赫。 袁女士告訴記者,到達成都后,當天一同乘車接受取卵的還有另外3名女子,車子行駛大約40分鐘后停了下來。 袁女士:我聽見開卷簾門的聲音,車子停進卷簾門里,卷簾門就拉下來了,我也不認得那些女的,人家是各個地方的,下車就去了,醫(yī)生在手術臺上是“全副武裝”的,看不到臉。 進行取卵手術后沒多久 李如志就告訴袁女士 胚胎培育成功 如果加錢還可以做雙胞胎 袁女士:說我們還需要再重新取卵,重新配一個給我們,我們說我們真的一分錢也拿不出來了。 輸卵管慘遭切除 當事人陷入胚胎培育“無底洞” 讓袁女士沒有想到的是,這次取卵后由于輸卵管積水,她的另一側輸卵管也被切除了,為此還四處借錢治療。袁女士說,等到身體恢復好后,李如志又對她說暫時不能移植胚胎。 就這樣,袁女士在保養(yǎng)子宮內(nèi)膜的路上又耗了近一年時間,期間還到李如志開設在觀山湖區(qū)富力中心的“生命醫(yī)療中心”進行婦科治療。 袁女士:醫(yī)生說子宮內(nèi)膜厚度達到7就可以移植了,我就反復問他們,為什么我的(子宮內(nèi)膜厚度)非要到8,他說8保險一點。 盡管多次到三甲醫(yī)院檢查 醫(yī)生都告知袁女士達到懷孕標準 但袁女士稱 這在李如志看來都不安全 袁女士:我現(xiàn)在總共交給他們十五萬二,我自己調理和在他們這里買的藥花了五六萬。 胚胎還沒移植成功,就已經(jīng)支出18萬余元,遠遠超出了袁女士的預算。然而,如果不繼續(xù)掏錢,似乎這胚胎就無法移植到體內(nèi)。由此,袁女士產(chǎn)生了疑慮。 袁女士:不值得信任了,這個胚胎有沒有,我們根本不知道。 就在袁女士選擇及時止損,并準備退款時,她發(fā)現(xiàn)這兩家公司都關門了。1月21日,記者來到李如志開設在觀山湖區(qū)富力中心的“生命醫(yī)療中心”,此時門上貼著“外出學習”的字樣。而“成都市中美新生醫(yī)院管理有限公司”,也已人去樓空。 記者:關了多久? 隔壁理發(fā)店老板:關了幾個月了。 無論是聯(lián)系袁女士取卵 進行胚胎培育 還是袁女士進行后期康復 都與一個叫李如志的人有關 隨后,記者通過袁女士提供的電話聯(lián)系了李如志。對方聲稱在泰國,一會說他是公司負責人, 一會又說只是普通工作人員。 關于袁女士做試管嬰兒的情況,李如志始終沒有正面回應。記者查詢發(fā)現(xiàn),與袁女士簽訂“試管嬰兒咨詢服務合同”的成都市中美新生醫(yī)院管理有限公司,法定代表人叫張朝科,并非李如志,而這家公司目前處于注銷狀態(tài)。 針對袁女士如今面臨的狀況 記者和她首先來到 觀山湖區(qū)衛(wèi)健局進行反映 (點擊查看完整視頻) 貴陽市觀山湖區(qū)衛(wèi)生健康局工作人員:就是這幾年,特別多,直接沒地方維權,報案又立不了案。 貴陽市觀山湖區(qū)衛(wèi)生健康局工作人員:特別難查,僅靠我們一個部門的話真的搞不定。 咨詢公司“見縫插針” 受害人維權四處碰壁 從交流中記者獲知,類似于袁女士的投訴并非個案。按照這名工作人員的說法,由于這些公司打著法律的擦邊球,執(zhí)法難度較大。 而經(jīng)過核查,袁女士在觀山湖區(qū)富力中心治療婦科的“生命醫(yī)療中心”,具有相關經(jīng)營資質。鑒于做試管嬰兒的咨詢合同是在南明區(qū)簽的,于是記者又來到南明區(qū)衛(wèi)健局反映情況。工作人員表示,他們已經(jīng)實地去查看過。 南明區(qū)衛(wèi)健局綜合行政執(zhí)法大隊副隊長 田軍:他已經(jīng)關門幾個月了。但是他這個什么都沒有,行醫(yī)行為都不在我們這邊,所以說我們這邊沒有辦法。 這名工作人員告訴記者,成都市中美新生醫(yī)院管理有限公司屬于咨詢服務公司,具體業(yè)務不在他們的管轄范疇,而袁女士取卵的行醫(yī)過程是在成都進行的,因此他們也無能為力。隨即,記者又來到南明區(qū)市場監(jiān)督管局,希望了解這家公司的具體情況,工作人員立即去現(xiàn)場進行了查看。 南明區(qū)市場監(jiān)督管局 辦公室主任:我們?nèi)タ戳耍?/span>公司已經(jīng)不在了,我們?nèi)ノ飿I(yè)問了,這家公司叫貴州恩享新生醫(yī)院管理有限責任公司。 原來,與袁女士簽定合同的是成都市中美新生醫(yī)院管理有限公司,而實際對外辦公的是貴州恩享新生醫(yī)院管理有限責任公司。經(jīng)過查詢記者發(fā)現(xiàn),貴州恩享新生醫(yī)院管理有限責任公司的其中一名股東,就有一個叫李如志的人。 貴陽市南明區(qū)市場價監(jiān)督管理局辦公室主任:我們看他們登記內(nèi)容不涉及非法項目,都是國家標準經(jīng)營范圍,辦理執(zhí)照的手續(xù)也沒有什么問題。我們到現(xiàn)場去核查,他已經(jīng)有不在現(xiàn)場經(jīng)營的情況,我們也無法聯(lián)系,我們準備把他列入經(jīng)營異常名錄。 根據(jù)袁女士的講述,無論是她到成都取卵,還是后期到“生命醫(yī)療中心”進行治療,包括胚胎移植問題,都與李如志有關。由于對方拒不見面,2月6日,無奈的袁女士夫妻只得到貴陽中華南路派出所報案。 袁女士:連筆錄都沒做,看完合同就說根本立不了案,說人家咨詢公司是為我們服務了的。 一番反映下來 袁女士發(fā)現(xiàn)自己 維權舉步維艱,處處碰壁 實際上 和袁女士有類似經(jīng)歷的 還有曾師傅夫婦和張先生夫婦 他們做試管嬰兒時的遭遇 同樣讓人震驚 那么 在他們的身上又發(fā)生了什么?

·請注意語言文明,尊重網(wǎng)絡道德,并承擔一切因您的行為而直接或間接引起的法律責任。
·長沙社區(qū)通管理員有權保留或刪除其管轄留言中的任意非法內(nèi)容。